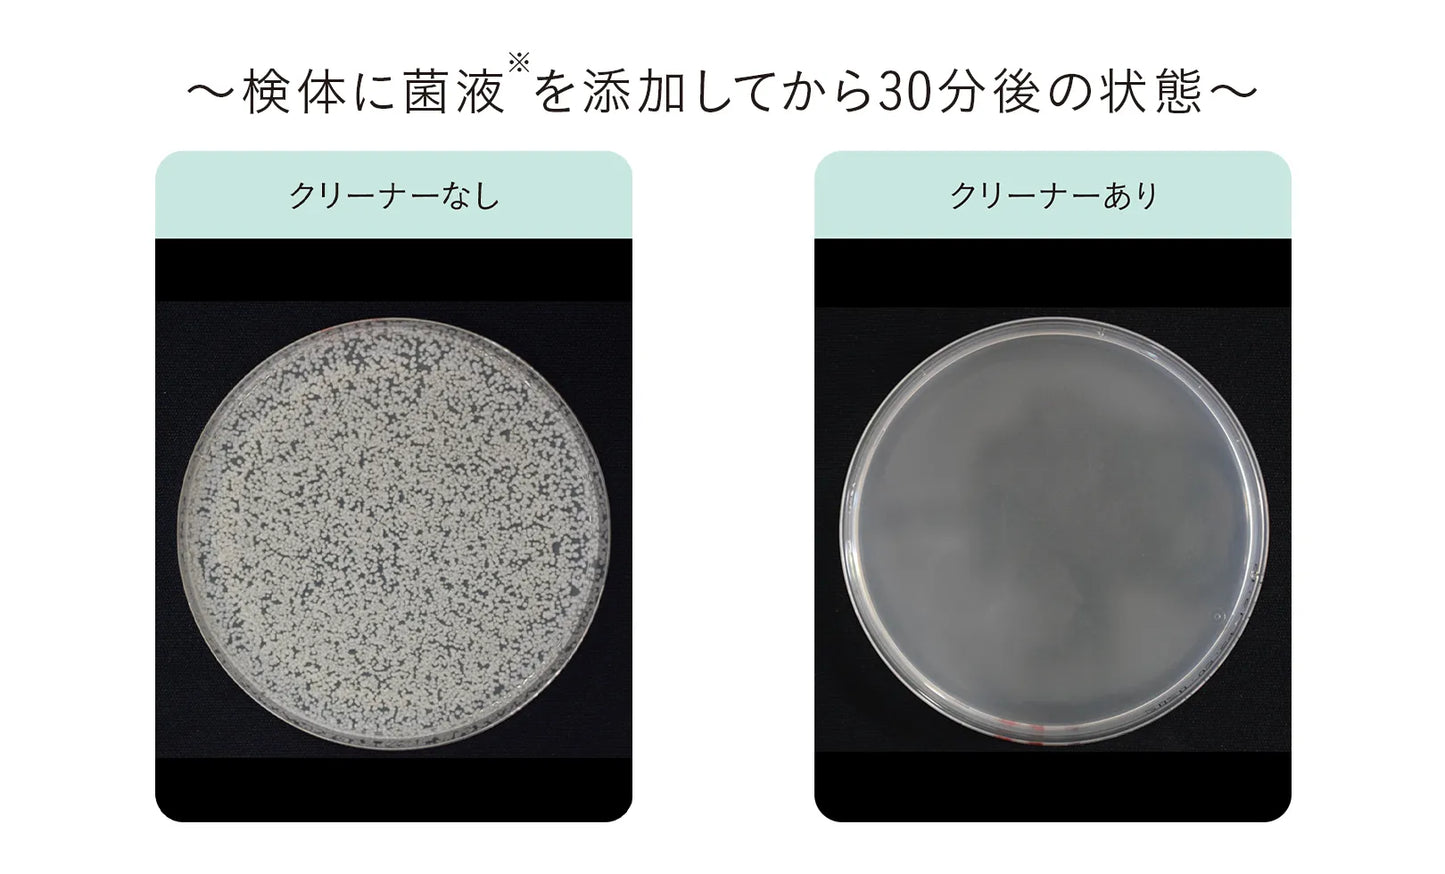

1
/
の
4
FeMirin-anjo
【iroha】 ITEM CLEANER
【iroha】 ITEM CLEANER
通常価格
¥1,100 JPY
通常価格
セール価格
¥1,100 JPY
単価
/
あたり
税込。
配送料はチェックアウト時に計算されます。
受取状況を読み込めませんでした
ワンプッシュで出てくるふわふわの泡をアイテムに付けて、
ティッシュなどで拭き取るだけの簡単ケア。
銀イオンと、マイルド殺菌成分イソプロピルメチルフェノール配合で、
大切なアイテムを除菌します。
さらに、弱酸性でできているから、
プレジャータイムの前後を選ばずご使用いただけます。
検体に菌液(※1)を添加してから30分後の状態
※1 カンジダ菌
※ 全ての菌を除菌するわけではありません
※ この他、大腸菌、黄色ブドウ球菌でも同様の効果を認めました
※「日本薬局方参考情報 消毒剤の評価法」に基づく試験結果
※ 試験機関:株式会社衛生微生物研究センター
メーカー :iroha
商品名 : ITEM CLEANER
JANコード :4570030973279
発送目安 :ご注文後2~3日
Share